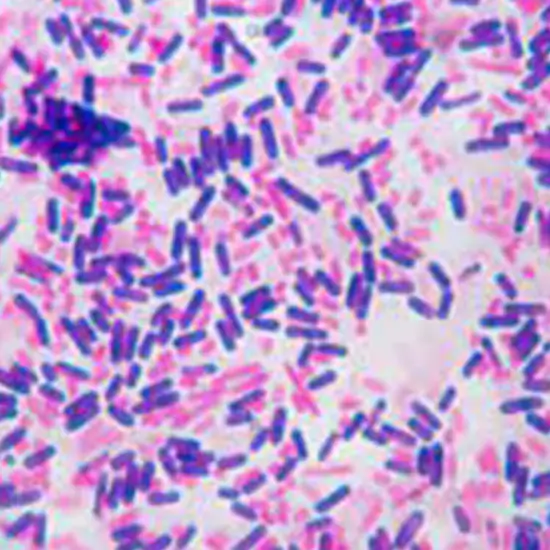

Book Gram Stain Bacteria Test Appointment Online Near me at the best price in Delhi/NCR from Ganesh Diagnostic. NABL & NABH Accredited Diagnostic centre and Pathology lab in Delhi offering a wide range of Radiology & Pathology tests. Get Free Ambulance & Free Home Sample collection. 24X7 Hour Open. Call Now at 011-47-444-444 to Book your Gram Stain Bacteria Test at 50% Discount.
Gram Stain Bacteria test is a blood test which helps in determining the presence of the bacteria at the site of suspected infection.this test is used to diagnose whether there is any harmful microorganism present inside the body such as bacteria. This test is generally ordered by the doctors in case of suspicion of a bacterial infection.
The process involves applying the sample of body fluid on a glass slide then allowing it to dry then a stain is applied on the glass slide and later evaluated under a microscope . the presence of bacteria is categorised by its colour on the slide
In the diagnosis of specific microorganisms causing the infection: as soon as a microorganism enters into our blood our body starts reacting towards it and if left untreated it can lead to serious infections such as septicemia. Specific medicines are available to target different microorganism therefore it is very essential to identify that what kind of microorganism is causing the infection so that the treatment can be done accordingly
Choosing the right antibiotics: As soon as the causative organism is found out the clinicians can choose the right antibiotic for the treatment.it is a well known fact that treating a bacterial infection with a wrong antibiotic and misuse of antibiotic can leads to antibiotic resistance therefore selecting the correct antibiotic with the appropriate dose is a must
Source of infection: this test can help in identifying the source from where the infection is coming for example whether it is originating from the urinary tract or respiratory system
Gram Stain Bacteria test is ordered by the doctor when the patient is showing the symptoms of bacterial infection such as :
Your healthcare provider will obtain a sample from the site of suspected infection some ways of obtaining a sample are listed below :
After collecting the required sample it is then sent to the lab where further analysis is done
The Gram Stain Bacteria test shows the two categories positive gram stain and negative gram stain and you should not get confused it with gram positive bacteria and gram negative bacteria
Positive Gram Stain: if your test results are positive then it indicates the presence of bacterial infection. the positive test result also includes the following information:
Negative Gram Stain: it may indicate that there are very few bacteria in your sample and couldn't be detected with gram stains; other tests such as bacterial culture test is needed for confirmatory diagnosis.
The price may vary based on the location and reputation of the diagnostic centre. The average price is around 200 to 500 Rs but you can book this test at ganesh diagnostic centre and get a heavy discount.
Gram stain bacteria test is important because this test contributes to the confirmation of data that helps medical professionals choose the best course of action for treating patients, enhancing patient outcomes, and stopping the spread of infections throughout the body. Early identification and suitable handling of bacterial infections are essential for patient health.
| Test Type | Gram Stain Bacteria Test |
| Includes | Gram Stain Bacteria Test (Pathology Test) |
| Preparation | |
| Reporting | Within 24 hours* |
| Test Price |
₹ 175
|

Gram Stain Bacteria test is a diagnostic tests which is done to identify the presence of bacterial infection.
Mainly there are two types of bacteria-
Yes , ganesh diagnostic centre provides a Gram Stain Bacteria test at home service without any hidden charges
The gram stain bacteria test has no normal range as the result only says ;positive gram stain or negative gram stain report..
The cost of Gram Stain Bacteria test vary depend on the location of the diagnostic centre you can book this test at a heavy discount only at ganesh diagnostic centre.
No, fasting is not required for Gram Stain Bacteria test
You can download your Gram Stain Bacteria test report online from our website.
Gram Stain Bacteria test result shows the positive or negative status , positive result indicates the presence of infection and the negative result indicates that there is no bacterial infection.
You can type an Gram Stain Bacteria test near me in Google search for the nearest centres available or call our customer executive at 011-47-444-444 / 011-47-333-333 for detailed information.
Ganesh Diagnostic centres are present in Rohini, Nangloi, Model Town, Hari Nagar, Mangol Puri and Yamuna Vihar.
Gram Stain Bacteria test is a diagnostic tests which is done to identify the presence of bacterial infection.
Mainly there are two types of bacteria
Yes , ganesh diagnostic centre provides a Gram Stain Bacteria test at home service without any hidden charges.
The gram stain bacteria test has no normal range as the result only says ;positive gram stain or negative gram stain report.
The cost of Gram Stain Bacteria test vary depend on the location of the diagnostic centre you can book this test at a heavy discount only at ganesh diagnostic centre.
No, fasting is not required for Gram Stain Bacteria test.
You can download your Gram Stain Bacteria test report online from our website.
Gram Stain Bacteria test result shows the positive or negative status , positive result indicates the presence of infection and the negative result indicates that there is no bacterial infection.
You can type an Gram Stain Bacteria test near me in Google search for the nearest centres available or call our customer executive at 011-47-444-444 / 011-47-333-333 for detailed information.
Ganesh Diagnostic centres are present in Rohini, Nangloi, Model Town, Hari Nagar, Mangol Puri and Yamuna Vihar.
Early check ups are always better than delayed ones. Safety, precaution & care is depicted from the several health checkups. Here, we present simple & comprehensive health packages for any kind of testing to ensure the early prescribed treatment to safeguard your health.